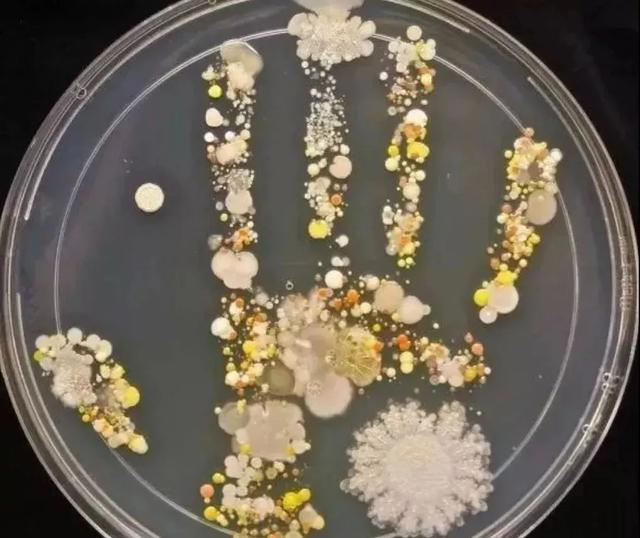
酒精棉片是干什么用的，酒精棉片是干什么用的杂牌（外出好物“酒精棉片”）

百科生活 投稿
关于【酒精棉片是干什么用的】:酒精棉片是干什么用的,今天小编给您分享一下,如果对您有所帮助别忘了关注本站哦。
- 内容导航:
- 1、酒精棉片是干什么用的
- 2、外出好物“酒精棉片”,用它轻轻一擦,干净又卫生
1、酒精棉片是干什么用的
消毒杀菌的。在医院中通常是用作注射前的皮肤擦拭,手术前工具的擦拭消毒,新生儿剪肚脐时也可用酒精棉消毒。中医拔罐也用到酒精棉,蘸上95%的乙醇后,点燃酒精棉后可以用于拔罐,洁净无污染而且方便。酒精棉一般是由洁净棉花蘸75%左右的医用酒精溶液制成。中医拔罐用的酒精棉一般是蘸90%以上的酒精溶液。
除了在医院用到外,在生活中它也发挥了很大的用途。最简单的是用来清创和防感染之用了。如不小心擦伤或割破了皮肤,可以先用酒精棉片在伤口周围的皮肤上擦拭一下,然后在贴上创可贴,这样既保险又舒适,防止了细菌的入侵。青春期脸上可能会长痘痘,这时随身携带几片酒精棉片,经常擦拭一下皮肤,既清除了不适,而且可以防止因用手去抓而引起的交叉感染。打了耳洞后容易引起耳朵发炎,早晚一擦很快就消炎了。
2、外出好物“酒精棉片”,用它轻轻一擦,干净又卫生
时代在发展,生活节奏越来越快,认真算下来的话,我们每个人平均每天都要接触物体好几百次,摸脸数十次,说白一点,这真的很不卫生。
大人还好,小孩子压根不会想那么多,更别提勤洗手了,只能我们去注意去照顾。
带细菌的手
像日常生活中我们接触最多的就是手机、电脑、办公桌、餐具等物品,而这些正是容易滋生细菌的地方。
很多人都会觉得厕所马桶非常脏,其实不然,从细菌的数量上看,手机比马桶更脏。
小时候经常被爸妈念叨要“勤洗手”,但总是习惯性忽视,现在才知道做好卫生有多重要。
但平时总有不方便洗手的时候,如何才能保护自己不被细菌伤害呢?
今天小编给大家带来了一款最新上线的居家好物:云南白药酒精棉片(浓度75%)+消du湿巾。

这是个组合装,组合之一的酒精棉片浓度为75%!一盒有50片,尺寸是150mmX12mm,用来日常清洁消du非常方便。

而且它的内芯采用的还是透气无纺布,柔软亲肤,携带方便,不易挥发。
像我们日常都会接触到电梯、门把手、共享单车、手机等等物品,使用后都有必要用酒精棉片来清洁,保证卫生安全。

文末可抢购
买不到免洗洗手液的人,这个酒精棉片就能帮上大忙,放在包里相当稳妥,有效预防交叉感染,放心出门。

用这种75%的酒精消du手部,可以在短短几秒内带走各种细菌,而且用后免洗手,方便又卫生。
特别是24小时不离身的手机,更应该多酒精棉片擦一擦,以绝后患。
而且云南白药也是个老字号了,它家出品的酒精棉片是不含人工香料、荧光剂、防腐剂的,质量非常有保障,用起来很放心。
文末可抢购
跟它组合搭配的另一个是家用消du湿巾。

它是一款医用级别的消du湿巾,内含主要成分苯扎氯铵更是常被用于手术器械的消du和保存,由此可见其要求有多严。

它能有效杀菌清洁,如大肠杆菌、金黄色普通球菌等。
除此之外它还添加了芦荟叶提取液和洋甘菊提取液,消毒洁净的同时还有滋养效果。
一盒有80抽,完全够用一阵子了,而且它用起来比75%酒精还温和,对皮肤不会引起灼伤感,非常适合给小朋友使用。
像它这种不含酒精的消d湿巾就适合在厨房等地方使用,用起来更安全。

文末可购买
尺寸是200mmX150mm,触感非常柔软,如布一样的湿巾,很耐撕、抗拉。
设计也非常合理,一抽一拉,安全卫生,还很耐用。
最后说重点!这款云南白药酒精棉片+湿巾现在刚好做活动,3盒酒精棉片+3盒消d湿巾=390片只要129元人民币!
2月19号发货,包邮,数量不多,抢完为止!点下发“了解详情”即可抢购↓
本文关键词:酒精棉片多少钱一盒,酒精棉片可以用于打针消毒吗,酒精棉片可以擦伤口吗,酒精棉片,酒精棉片可以擦脸吗。这就是关于《酒精棉片是干什么用的,酒精棉片是干什么用的杂牌(外出好物“酒精棉片”)》的所有内容,希望对您能有所帮助!
- 最近发表